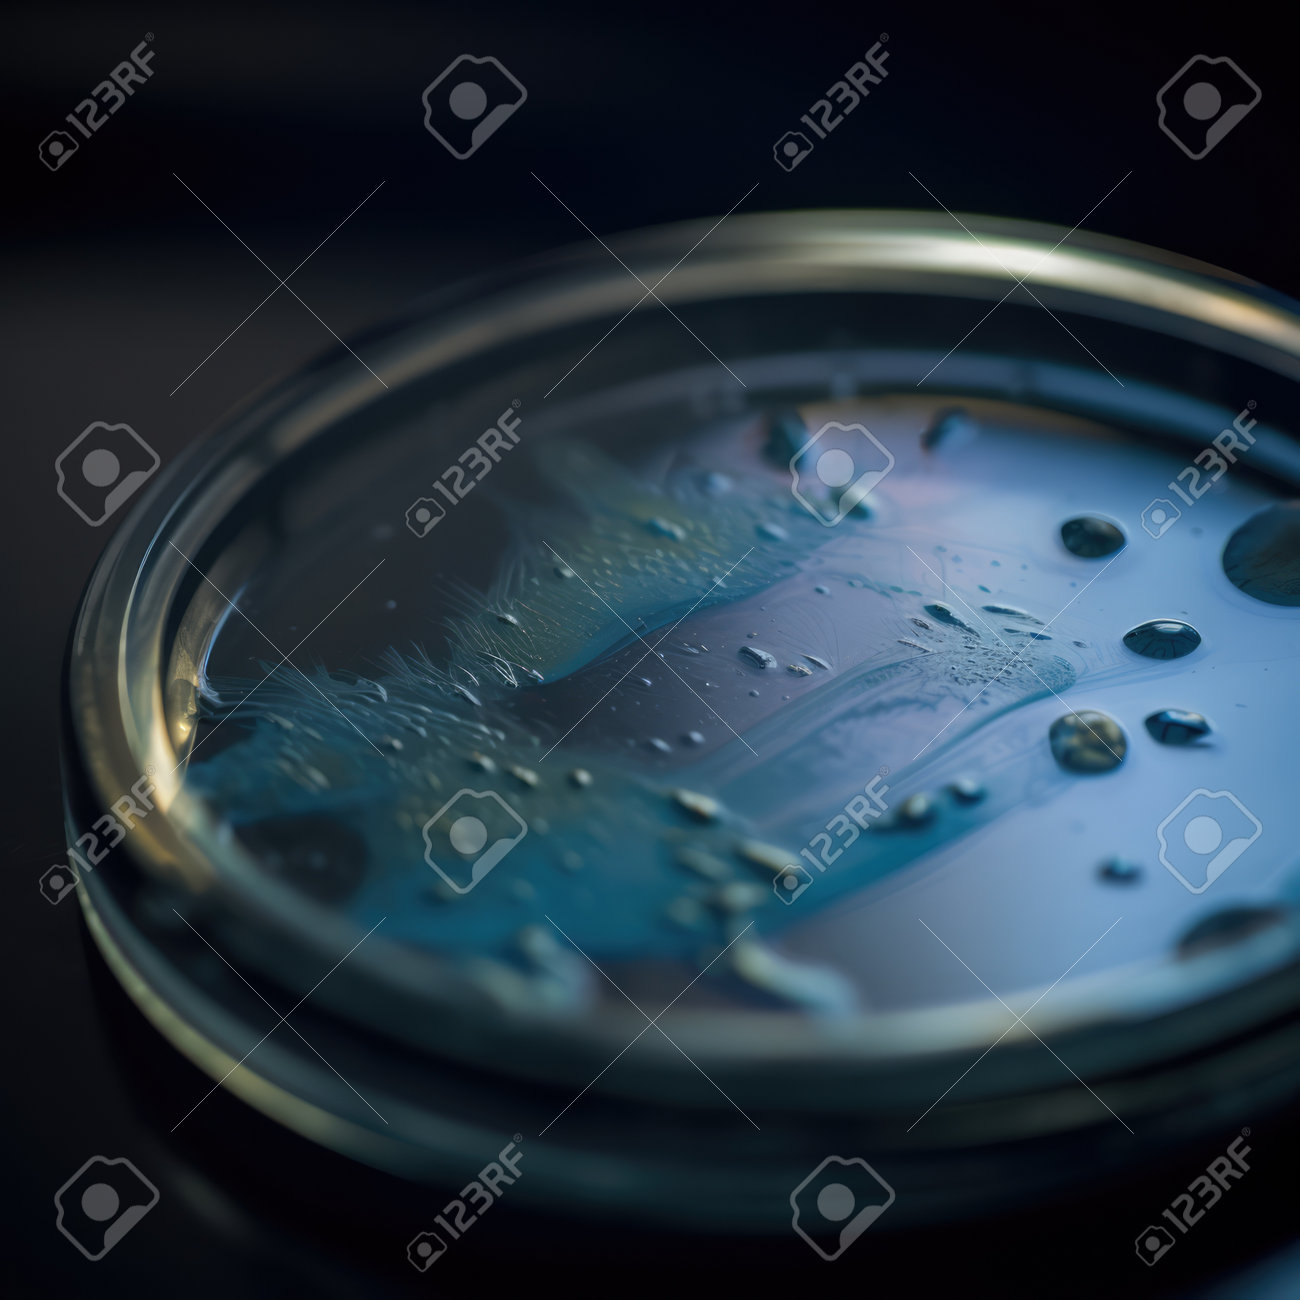
etiam-dictum-ipsum-a-felis

Download
Close
Автор:
id:
Ключевые слова:
ai, ai generated, background, bacteria, biology, black, black background, business, cell, cellphone, communication, computer, digital, digital animation, digital world, digitally, digitally generated, dish, generated, generated image, generative, generative ai, image, infection, internet, lab, microbe, microbiology, mobile, montage, no people, online, petri, phone, plate, science, science lab, smartphone, technology,





